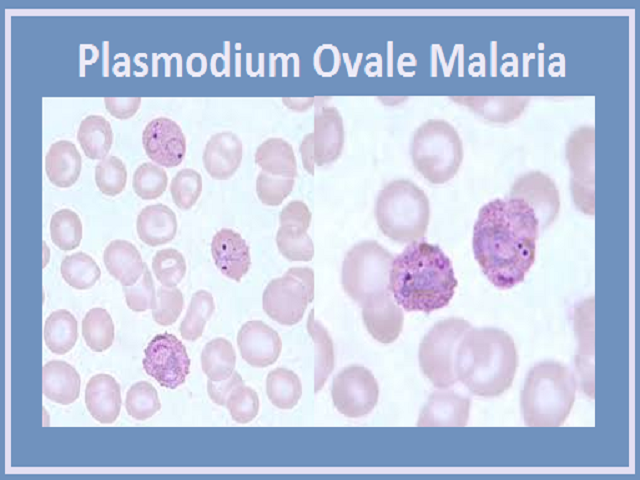

Simple / Classical Mixed Malaria
Mixed malaria occurs when a person is simultaneously infected with more than one species of Plasmodium parasite, most commonly P. vivax and P. falciparum.
Symptoms may be variable and severe, combining features of both intermittent and continuous fever patterns.
Patients often experience high fever, chills, anemia, weakness, and a higher risk of complications.
Diagnosis can be challenging and requires careful blood examination to identify multiple parasites.
From a homeopathic perspective, mixed malaria represents a complex disturbance of the vital force and needs careful, individualized constitutional treatment.
Simple / Classical Mixed Malaria Read Post »